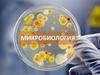
Микробиология

Похожие презентации:
Археи. 100 величайших открытий биологии
1.
Задачи:углубить знания о многообразии органического
мира
ознакомить с трех доменной системой
органического мира Карла Везе
дать понятие о строении и жизнедеятельсти архей
развивать познавательный интерес, расширить
кругозор
Воспитывать ответственность,
2.
«100 величайших открытий биологии». АРХЕИ3.
Археи (лат. Archaea от др.-греч. ἀρχαῖος «извечный,древний, первозданный, старый») Термин «архей»
предложил в 1872 году американский геолог Джеймс Дана
Домен живых организмов по трёхдоменной системе Карла
Вёзе наряду с бактериями и эукариотами)
Археи представляют собой одноклеточные
микроорганизмы, не имеющие ядра , а также какихлибо мембранных органелл.
4.
Трехдоменная система Карла Везе5.
Домены — относительно новый способклассификации. Трёхдоменная система
изобретена в 1990 году, однако до сих пор не
принята окончательно. Одной из главных
особенностей трёхдоменного метода является
разделение археев ( Archaea ) и бактерий
(Bacteria), которые ранее были объединены в
царство бактерий. Существует так же малая
часть учёных, добавляющих археев в виде
шестого царства, но не признающих домены.
6.
Установлено, чтоархеи имеют
свою
независимую
эволюционную
историю и
характеризуются
многими биохим
ическими
особенностями,
отличающими их
от других форм
жизни.
7.
Биографические данныеКарл Ричард Везе родился 15 июля
1928 в городе Сиракузы, штат НьюЙорк . Американский микробиолог,
знаменитый по определению архей
(нового домена живых организмов).
В настоящее время Везе профессор микробиологии в
Университете Иллинойса в УрбанеШампейн.
8.
ТаксоныПРЕДЛОЖЕННЫЕ
Карлом Везе
9.
В настоящее время архей подразделяют на 5 типов:Кренархеоты (Crenarchaeota)
Эвриархеоты (Euryarchaeota)
Корархеоты (Korarchaeota)
Наноархеоты (Nanoarchaeota)
10.
Впервые археи былиобнаружены в экстремальных
местообитаниях, таких как
горячие вулканические
источники
,,,
Археи живут в широком
диапазоне сред обитания и
являются важной частью
глобальной экосистемы, могут
составлять до 20 % общей
биомассы. Экстремофилы выживают при высоких
температурах, часто свыше
100 °C, и обнаружены в
гейзерах, чёрных курильщиках
и маслосборниках
Мезофиллы – обитают в
мягких условиях, в болотистых
местностях, сточных водах,
океанах и почве
11.
Базофилы -Пятно цветных термофильных архей
Национальный парк Йеллоустон, США
приспособились к
жизни в очень
холодных условиях,
в сильносолёных,
сильнокислых и
сильнощелочных
средах, а также при
высоком давлении —
до 700 атмосфер
12.
ARMAN —новая группа
архей,
обитающая
в дренажных
кислых
шахтных водах
Археи - базофилы
13.
Формаархей
архейх
ей
Halobacteria
каждая клетка
около 5 мкм длиной
Отдельные клетки архей достигают от 0,1
до 15 мкм в диаметре и могут иметь
различную форму:
шара, палочки, спирали или диска.
Некоторые имеют другую форму,
например, Sulfolobus—дольчатой формы;
Thermofilum — тонкой нитевидной формы
Thermoproteus и Pyrobaculum почти
идеально прямоугольные
Haloquadratum walsbyi — плоские
квадратные
14.
Бактериии археи отличаются
строением и
размером РНК
У архей обнаружены
белки, родственные
компонентам
цитоскелета других
организмов, а также
показано присутствие
филаментов в их
клетках, однако у архей,
в отличие от других
организмов, эти
структуры плохо
изучены
15.
бинарное делениефрагментация
почкование
В отличие от бактерий
и эукариот, ни один
известный вид архей не
формирует спор
16.
Типы питания архей.Типы питания
Источники энергии
Источник углерода
Примеры
Фототрофы
Солнечный свет
Органические
соединения
Halobakteria
Неорганические
соединения
Органические
соединения или
фиксация углерода
Ferroglobus
Puroglobus
Metanobakteria
Органические
соединения
Органические
соединения или
фиксация углерода
Puroccocus
Sulfolobus
Metanosarcinales
Литотрофы
Органотрофы
17.
В наше время археи признаны важной составляющейжизни на Земле и играют роль:
В круговоротах углерода и азота
Ни один из известных представителей архей не
является паразитом или патогенным организмом
Часто бывают мутуалистами и комменсалами
Некоторые представители являются метаногенами и
обитают в пищеварительном тракте человека
и жвачных, где очень многочисленны и помогают
осуществлять пищеварение
Метаногены используются в производстве биогаза и
очистке канализационных сточных вод, а ферменты
экстремофильных бактерий, сохраняющие активность
при высоких температурах и в контакте с
органическими растворителями, находят своё
применение в биотехнологии
18.
Выберите правильные утверждения:• 1. Археи, как и бактерии, представляют собой
одноклеточные микроорганизмы, не имеющие ядра,
а также каких-либо мембранных органелл
• 2. Карл Вёзе предложил трёхдоменную систему:
археи, бактерии и эукариоты
• 3. Трехдоменная система общепринятая в науке
• 4. Археи легко выращиваются в лабораторных
условиях и хорошо изучены
• 5. Бактерии образуют споры, как и археи
• 6. Бактерии открыты и описаны Левенгуком
• 7. Археи могут жить в экстремальных условиях
• 8. Существует группа болезнетворных архей
• 9. В клетках архей и бактерий нет ядра
• 10. Бактерии и археи используются в биотехнологии
19.
Домашнее задание:• Повторение темы «Бактерии»
• Тема «Археи» изучение в сравнении по
записи в рабочей тетради
20.
Источники информации:• 1.Громов Б.В. Удивительный мир
архей // СОЖ. — 1997. — № 4. — С. 23—26.
• 2. elementy.ru/news
• 3. science.compulenta.ru/
• 4. ucheba-legko.ru
• 5. paranormal.org.ru
• 6. rasfun.ru
• 7. ru.wikipedia.org/wiki/Археи
• 8. ru.wikipedia.org/wiki/Трёхдоменная система
• 9. u.goldenmap.com/lenta.rulenta.rukemcbs.com
• 10.www.pereplet.ru/obrazovanie/stsoros




















 Биология
Биология